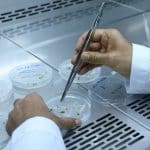
blank
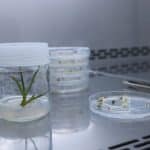
blank

Her türlü kuraklığa dayanıklı bitki üretecekler
Sivas Bilim ve Teknoloji Üniversitesi bünyesinde görev yapan iki akademisyen geliştirdikleri proje kapsamında kuraklığı dayanıklı bitki üretecekler.
Sivas Bilim ve Teknoloji Üniversitesi Tarım Bilimleri ve Teknoloji Fakültesi’nde görevli Prof. Dr. Tolga Karaköy ve Doç. Dr. Faheem Shahzad BALOCH tarafından geliştirilen ve Avrupa Birliği’nden fon sağlanan proje kapsamında hâlihazırdaki bitki türlerinin ıslah edilmesi ile kuraklığa dayanaklı daha uzun ömürlü türlerin ortaya çıkması sağlanacak. Geliştirilecek proje ile kuraklığın vurduğu tarım, hayvancılık gibi diğer alanlara da çare bulunarak çiftçilerin hayatı kolaylaştırılacak.
Kamuoyuna açıklamalarda bulunan proje yöneticisi Doç. Dr. Faheem Shahzad BALOCH, gelecekte baş gösterecek iklim değişiklikleri ile ilgili problemlerden yola çıkarak bu projeyi ortaya koyduklarını açıkladı.